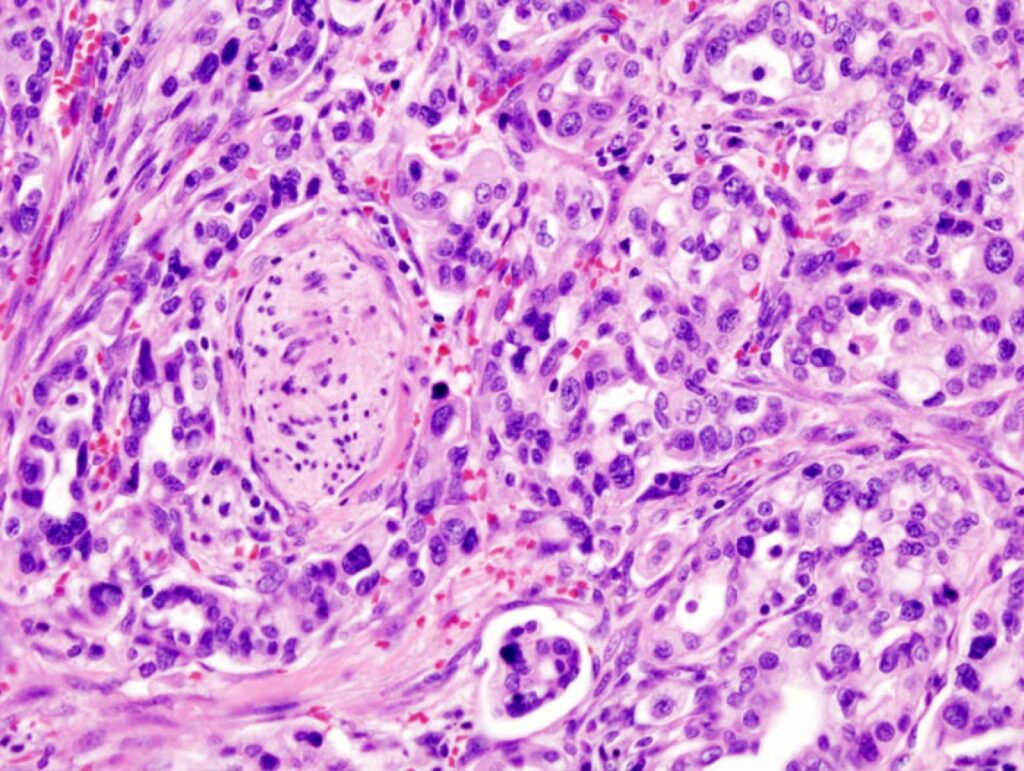

Pubblicato il 12/06/2024
Uno studio su Nature indaga le primissime fasi dello sviluppo del tumore del pancreas, cercando d’identificare alterazioni molecolari precoci che indichino l’inizio della progressione tumorale. I risultati evidenziano mutazioni nel gene KRAS e che ogni precursore è un evento indipendente dagli altri: non sono futuri tumori, ma popolazioni che potrebbero in effetti darvi origine.
Crediti immagine: Wikimedia Commons. Licenza: CC attribution-sharealike 3.0 unported
Dei meccanismi mediante i quali una cellula normale cambia il suo status e prende la via della trasformazione tumorale sappiamo molto: mutazioni in geni coinvolti nel controllo del ciclo cellulare, della proliferazione, nella rimozione di basi danneggiate o inserite in modo scorretto dal DNA, mutazioni che rendono questi geni non funzionali o troppo funzionali. Sappiamo molto anche di tutti gli eventi che consentono a un tumore di crescere, invadere, infiltrare, collegarsi al circolo ematico, diventare resistente alle terapie, disperdere metastasi.
[[{“value”:”di Ettore Meccia
Pubblicato il 12/06/2024
Uno studio su Nature indaga le primissime fasi dello sviluppo del tumore del pancreas, cercando d’identificare alterazioni molecolari precoci che indichino l’inizio della progressione tumorale. I risultati evidenziano mutazioni nel gene KRAS e che ogni precursore è un evento indipendente dagli altri: non sono futuri tumori, ma popolazioni che potrebbero in effetti darvi origine.
Crediti immagine: Wikimedia Commons. Licenza: CC attribution-sharealike 3.0 unported
Ricerca scientificaSaluteDei meccanismi mediante i quali una cellula normale cambia il suo status e prende la via della trasformazione tumorale sappiamo molto: mutazioni in geni coinvolti nel controllo del ciclo cellulare, della proliferazione, nella rimozione di basi danneggiate o inserite in modo scorretto dal DNA, mutazioni che rendono questi geni non funzionali o troppo funzionali. Sappiamo molto anche di tutti gli eventi che consentono a un tumore di crescere, invadere, infiltrare, collegarsi al circolo ematico, diventare resistente alle terapie, disperdere metastasi.”}]]









